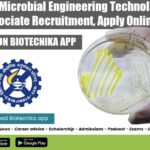
IMTECH Job Opening 2022

Home Search
biology - search results
If you're not happy with the results, please do another search
Student Internship With Stipend For MTech, MSc, BTech at CSIR-IITR
Student Internship With Stipend For MTech, MSc, BTech at CSIR-IITR
Student Internship With Stipend For MTech, MSc, BTech at CSIR-IITR. CSIR - Indian Institute of...
Biotecnika Times Newsletter 28.04.2022 FSSAI Internship, Govt OMFED QC Jobs, ICAR
Biotecnika Times - FSSAI Internship, Govt OMFED QC Jobs, ICAR
FSSAI Internship Scheme For May 2022 With Stipend, APPLICATION PORTAL OPEN
FSSAI Internship 2022 May Scheme,...
NCCS Pune Job 2022 – Research Associate, JRF & Project Associate Vacancies
NCCS Pune Job 2022 - Research Associate, JRF & Project Associate Vacancies
NCCS Pune Job 2022 - Research Associate, JRF & Project Associate Vacancies. NCCS...
ICAR Indian Institute of Millets Research Recruitment With Rs. 80,000 pm Pay
ICAR Millets Research Recruitment With Rs. 80,000 pm Pay
ICAR Millets Research Recruitment With Rs. 80,000 pm Pay. ICAR – Indian Institute of Millets Research...
WII Life Sciences & Botany Project Recruitment, Applications Invited
WII Project Vacancies 2022 For Life Sciences, Botany - Applications Invited
WII Project Vacancies 2022 For Life Sciences, Botany - Applications Invited. MSc & PhD...
CSIR-IMTECH Microbial Engineering Technology Project Associate Recruitment, Apply Online
IMTECH Job Opening 2022 - Project Associate Job Available
IMTECH Job Opening 2022 - Project Associate Job Available. Project Associate Recruitment. Interested and eligible applicants...
NIAB Research Associate Job For Life Sciences, Applications Invited
NIAB Research Vacancy 2022 For Life Sciences, Applications Invited
NIAB Research Vacancy 2022 For Life Sciences, Applications Invited. National Institute of Animal Biotechnology vacancies. MSc/...
Government Biological Sciences JRF Recruitment – Apply Online
Government Biological Sciences JRF Recruitment - Apply Online
Government Biological Sciences JRF Recruitment - Apply Online. Rajiv Gandhi Centre for Biotechnology MSc Biological Sciences Job....
Revise For NEET Exam 10 Times Faster – Top 10 Formula & Strategies
NEET Revision Tips - 10 Formula To Revise For NEET 10 Times Faster
There are many challenges faced by aspirants preparing for the NEET exam....
Smart Ways To Prepare For NEET Physics – Top 10 Strategies Discussed
NEET Physics Preparation Strategy - Top 10 Strategies Discussed
Most of the NEET aspirants believe that to become a doctor only an understanding of Biology...
Biotecnika Times Newsletter 27.04.2022 Govt OMFED Recruiting, Bureau of Indian Standards
Biotecnika Times - Govt OMFED Recruiting, Bureau of Indian Standards
Bureau of Indian Standards (BIS) Recruitment 2022, Online Applications Invited
BIS Jobs 2022 - Bureau of...
Karnatak University PhD Admissions – Applications Invited
Karnatak University PhD Admissions - Applications Invited
Karnatak University PhD Admissions - Applications Invited. Applied Genetics PhD Positions Available. Check details on the same below
This...
ICAR-DFMD mRNA Vaccine Project JRF Job Opening, Applications Invited
ICAR-DFMD JRF Job For MSc, MTech - Applications Invited
ICAR-DFMD JRF Job For MSc, MTech - Applications Invited. Project Junior Research Fellow Job Openings. Interested...
Tezpur University Breast Cancer Project JRF Job Opening, Applications Invited
Tezpur University Project JRF Job Opening, Applications Invited
Tezpur University Project JRF Job Opening, Applications Invited. MSc JRF Vacancy at Tezpur University. Interested and eligible...
Tata Institute for Genetics & Society Research Job 2022 For Biological Sciences
TIGS Biological Sciences Vacancy - Applications Invited Online
TIGS Biological Sciences Vacancy - Applications Invited Online. MSc Biological Sciences Apply. Interested and eligible applicants can...